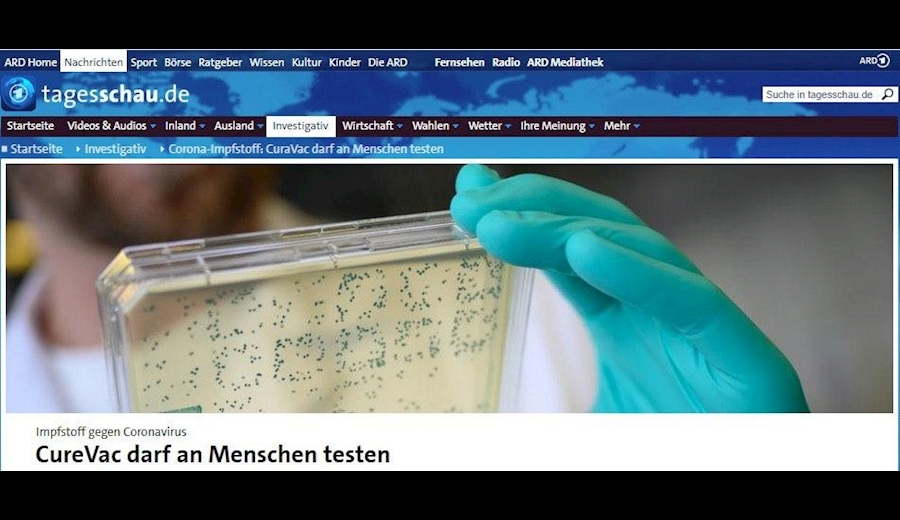
بیش از ۸ میلیون و ۳۲۲ هزار نفر مبتلا به کرونا

آخرین اخبار مربوط به کووید ۱۹ در جهان
بیش از ۸ میلیون و ۳۸۹ هزار نفر مبتلا به کرونا
شمار مبتلایان به ویروس کرونا در جهان، به ۸ میلیون و ۳۸۹ هزار و ۶۱۴ نفر افزایش یافته و شمار جان باختگان به ۴۵۰ هزار و ۳۹۸ تن رسیده است.
به گزارش سرویس بین الملل خبرگزاری صدا و سیما، جدیدترین خبرها درباره شیوع ویروس کرونا در جهان و تحولات مربوط به آن به شرح زیر است:

پکن در شرایط بحرانی
با توجه به ورود دوباره کرونا به شهر پکن و افزایش شمار مبتلایان، این شهر در شرایط حساسی قرار گرفته و آن طور که کارشناسان بهداشتی چین میگویند سه روز آینده برای ساکنان پایتخت بسیار حیاتی است.
موارد جدید از ابتلا به کرونا در پکن
خبرگزاری رویترز گزارش داد: وزارت بهداشت چین روز چهارشنبه، ۲۱ مورد جدید از ابتلا به بیماری کرونا را در پکن گزارش داد.
شمار مبتلایان به کرونا در پکن در روز سه شنبه ۳۱ نفر بود.
از آغاز مجدد شیوع کرونا در پکن در هفته گذشته میلادی، تاکنون ۱۵۸ نفر مبتلا به این بیماری شناسایی شده اند.
اعتراض کرونایی رانندگان اتوبوس در برلین
عدهای از رانندگان اتوبوس به دلیل محدودیتهای سفر در دوره شیوع کرونا و کاهش درآمدشان در برلین دست به اعتراض زدند.
به گزارش خبرگزاری صدا و سیما از برلین در این تجمع رانندگان با ۱۰۰۰ اتوبوس از مناطق مختلف آلمان در پایتخت حضور یافتند و با به صدا درآوردن بوق خودروهایشان و ایجاد ترافیک سنگین اعتراض کردند.
نیمی از شرکتهای اتوبوس رانی در آلمان به خاطر بحران کرونا نگران ورشکستگی هستند.
بایدن: این رئیس جمهور (ترامپ) نتوانسته کشور ما را رهبری کند
جو بایدن نامزد حزب دموکرات در انتخابات ریاست جمهوری آمریکا در واکنش به گزارش سی ان ان مبنی بر احتمال مرگ ۲۰۰ هزار آمریکایی به علت ابتلا به ویروس کرونا تا ماه اکتبر در حساب توئیتری خود نوشت: دونالد ترامپ متخصصان را نادیده گرفت، تهدید ناشی از کووید-۱۹ را کم اهمیت جلوه داد و نتوانست اقدامات لازم را برای مهار آن به عمل آورد و در حال حاضر در بسیاری از ایالتها موارد ابتلا به کووید-۱۹ بار دیگر در حال افزایش است. این رئیس جمهور نتوانسته است کشور ما را رهبری کند.

از بیم گسترش ویروس در شماری از شهرهای روسیه مراسم رژه لغو شد
به گزارش خبرگزاری فرانسه از مسکو، شهر پتروزاودسک روسیه روز چهارشنبه رژه نظامی را که قرار بود ۲۴ ژوئن برای گرامیداشت پیروزی بر نازیها برگزار کند، از بیم آلودگی به ویروس کرونا لغو کرد. مقامات جمهوری کارلیا که پتروزاودسک مرکز آن است، در بیانیهای خاطر نشان کردند ”اختیار داشتند این تصمیمات را به طور مستقل در اوضاع همه گیری که برگزاری مراسم یادبود را نیز شامل میشود، اتحاذ کنند“.
رژه قرار بود برای جشن هفتاد و پنجمین سالگرد پایان جنگ جهانی دوم برگزار شود که به ویژه اعلام شده بود امسال با شکوهتر برگزار میشود. این مراسم نخست قرار بود نهم ماه مه برگزار شود، اما به علت شیوع ویروس کرونا به تعویق افتاده بود. ولادیمیر پوتین، رئیس جمهور روسیه در پایان ماه مه اعلام کرده بود بعد از ”گذشت“ اوج همه گیری، ۲۴ ژوئن رژه برگزار خواهد شد.
از آن زمان تاکنون به رغم اطمینانی که کرملین درباره اوضاع همه گیری در کشور داده بود، دست کم ۱۶ شهر و شش منطقه روسیه اعلام کرده اند این مراسم را برگزار نمیکنند. از اورال تا سیبری و کنارههای اقیانوس آرام روسیه همه بخشهای کشور این مراسم را لغو کرده اند.
اکثر اسپانیاییها، تابستان امسال به تعطیلات نخواهند رفت
به گزارش خبرگزاری فرانسه از مادرید، بر اساس یک نظرسنجی که روز چهارشنبه منتشر شد، بیش از دو سوم اسپانیاییها برغم لغو تقریبا کامل قرنطینه فکر نمیکنند تابستان امسال به تعطیلات بروند و آنهایی نیز که پیش بینی میکنند تعطیلات بروند، اکثریت بالایی از آنها در کشور خود خواهند ماند.
بر اساس نظرسنجی ماهانه مرکز تحقیقات اجتماعی که ارگانی دولتی است و در این نظر سنجی از چهار هزار و ۲۵۸ نفر نظرسنجی کرده است، حدود ۶۷ و ۷ دهم درصد پرسش شوندگان اعلام کرده اند قصد ندارند تابستان امسال به تعطیلات بروند و ۷ درصد نیز هنوز تردید دارند.
از ۲۷ و ۲ دهم درصدی که اعلام کرده اند از تعطیلات خود استفاده خواهند کرد، نزدیک به ۹۰ درصد گفته اند در اسپانیا باقی خواهند ماند و فقط ۶ درصد پیش بینی میکنند به خارج سفر کنند و این در حالی است که ۲ و ۵ دهم درصد نیز اعلام کرده اند از ترکیبی از این دو گزینه استفاده خواهند کرد.
اسپانیاییها به طور سنتی بخش اعظم تعطیلات تابستانی خود را در خارج از کشور میگذرانند. ۸۳ درصد پرسش شوندگان اعلام کرده اند در تعطیلات امسال در نظر دارند با خودرو شخصی خود سفر بروند، این در حالی است که ۲۱ و ۶ دهم درصد نیز با وسایل حمل نقل عمومی از جمله هواپیما، قطار، اتوبوس یا کشتی سفر خواهند کرد.
بخش گردشگری اسپانیا که دومین مقصد گردشگری جهان به شمار میرود، به شدت از قرنطینه و محدودیتهای سفر که در سراسر جهان اعلام شده بود، صدمه دیده است، به تقاضای داخلی برای نجات فصل تابستانی که مصیبت بار اعلام شده، امیدوار است. اسپانیا که یکی از کشورهایی است که بیشترین خسارت را از همه گیری متحمل شده و بیش از ۲۷ هزار نفر بر اثر ابتلا به کرونا جان باخته اند، روز یکشنبه مرزهای خود را با کشورهای اتحادیه اروپا به غیر از پرتغال بازگشایی کرد. اسپانیا برای بازگشایی مرز خود با پرتغال تا یکم ژوئیه منتظر خواهد ماند.
افزایش بی سابقه شیوع کرونا در ساحل عاج
به گزارش خبرگزاری صدا و سیما از ابیجان؛ نخستین بار در ساحل عاج شمار مبتلایان به ویروس کرونا در یک روز از مرز ۳۰۰ نفر عبور کرد. با ابتلای ۳۸۴ مورد جدید در روز چهارشنبه، شمار مبتلایان در این کشور به ۶۰۶۳ نفر رسید که نزدیک به نیمی از آنها، بهبود یافته و ۴۸ نفر فوت شده اند.
بر همین اساس، ۲۳ مورد ابتلای جدید در شهر بواکه دومین شهر بزرگ ساحل عاج گزارش شده است. افزایش شمار آزمایشهای روزانه به بیش از هزار آزمایش در روز، از سرگیری نسبی فعالیتهای اقتصادی و اجتماعی، و شروع فصل باران و در نتیجه افزایش سرمای هوا، به عنوان دلایل اوج گیری شیوع ویروس کرونا در ساحل عاج مطرح شده اند.
ایرفرانس به زودی چندین هزار فرصت شغلی را حذف میکند
شبکه خبری فرانسوی اوئست فرانس روز چهارشنبه در صفحه کاربری خود در توئیتر نوشت: شرکت هواپیمایی ایر فرانس قرار است به زودی حذف چندین هزار فرصت شغلی را به طور داوطلبانه اعلام کند. ۸۰۰۰ تا ۱۰ هزار شغل در معرض خطر قرار دارد. این اقدام برای مقابله با بحران ناشی از کرونا انجام میگیرد.
انتقاد شومر از محتوای نشست های خبری ترامپ
سناتور چاک شومر، رئیس اقلیت دموکرات در سنای آمریکا در حساب توئیتری خود نوشت: ترامپ بیشتر نشستهای خبری خود را به بد جلوه دادن معترضین مسالمت آمیز، انتشار ایرادات غیرقابل توجیه و پیشنهاد دادن اینکه واکسن ایدز به ساخت واکسن کرونا منجر میشود، اختصاص میدهد در حالی که هنور بیماری ایدز، واکسنی ندارد!
ثبت ۳۰ مورد جدید ابتلا به کرونا در یمن در ۲۴ ساعت گذشته
به گزارش شبکه تلویزیونی الجزیره، وزارت بهداشت یمن از ثبت ۳۰ مورد جدید ابتلا به کرونا در ۲۴ ساعت گذشته در این کشور به عنوان بالاترین آمار روزانه ابتلا به این ویروس از زمان شیوع تا کنون خبر داد.
شمار مبتلایان به کرونا در جمهوری آذربایجان به ۱۰۹۹۱ نفر رسید
به گزارش خبرگزاری صدا وسیما از باکو به نقل از ستاد ویژه مبارزه با کرونا در جمهوری آذربایجان، در ۲۴ ساعت گذشته، ۳۲۹ بیمار قطعی آلوده به ویروس کرونا شناسایی شدند که به این ترتیب، تعداد مبتلایان به ۱۰۹۹۱ نفر رسید. براساس این گزارش، با مرگ ۷ نفر دیگر بر اثر ابتلا به کرونا، تعداد جان باختگان هم به ۱۳۳ نفر افزایش یافت.

با پیوستن ۱۲۷ بیمار دیگر به جمع بهبودیافتگان، مجموع بهبودیافتهها به ۶۰۷۵ نفر شد. هم اکنون، ۴۷۸۳ مبتلا به کرونا در بیمارستانهای این کشور بستری و دوره درمان را سپری میکنند. در جمهوری آذربایجان، تاکنون ۳۹۷ هزار و ۳۹۹ مورد تست کرونا انجام گرفته است.
رئیس جمهور هندوراس بستری شد
خبرگزاری رویترز گزارش داد: رئیس جمهور هندوراس به علت ابتلا به کرونا بستری شد.
شمار مبتلایان در فرانسه ۵۴۲ نفر افزایش یافت
خبرگزاری رویترز گزارش داد: شمار مبتلایان به بیماری کرونا در فرانسه از ۱۵۷ هزار و ۱۷۴ نفر در روز سه شنبه به ۱۵۷ هزار و ۷۱۶ نفر رسید.
فرماندار نیویورک آمریکا، ۱۰۰ روز گذشته را جهنمی توصیف کرد
به گزارش شبکهای بی سی نیوز، اندرو کومو فرماندار نیویورک در پاسخ به این سئوال گوینده برنامه "صبح به خیر " شبکهای بی سی نیوز که از وی پرسید صد روز گذشته در این ایالت درباره شیوع کرونا را چگونه توصیف میکنید، پاسخ داد: جهنمی!
مجوز دومین شرکت آلمانی برای آزمایش واکسن کرونا
به گزارش خبرگزاری صدا و سیما از برلین؛ دومین شرکت آلمانی مجوز آزمایش واکسن کرونا روی انسان را از دولت فدرال آلمان دریافت کرد. شرکت آلمانی کیور وَک (CureVac) قرار است نخستین نتایج آزمایشها روی ۱۶۸ فرد را در ماههای سپتامبر و اکتبر (شهریور و مهر) امسال در دسترس قرار دهد. بنا به اعلام این شرکت مرحله بعدی این آزمایشها روی ۱۵ تا ۲۰ هزار نفر داوطلب انجام خواهند شد.

این شرکت اعلام کرد که توان تولید بیش از ۲۰۰ میلیون دُز واکسن را دارد. دولت آلمان قرار است با خرید ۲۳ درصد از سهام این شرکت به مبلغ ۳۰۰ میلیون یورو از تحقیقات آن ساخت واکسن کرونا حمایت کند نخستین شرکت آلمانی که مجوز آزمایش واکسن کرونا را دریافت کرد، شرکت بیون تک Biontech بود. هم اکنون ۱۳۹ شرکت دارویی درجهان در حال پژوهش روی تولید واکسن کرونا هستند.
شمار قربانیان همه گیری کووید ۱۹ در انگلیس از ۴۲ هزار نفر فراتر رفت
به گزارش خبرگزاری صدا و سیما از لندن، با جان باختن ۱۸۴ نفر دیگر در ۲۴ ساعت گذشته، شمار قربانیان همه گیری ویروس کرونا بر اساس امار دولتی هم به ۴۲ هزار و ۱۵۳ نفر رسید. وزارت بهداشت انگلیس امروز اعلام کرد همچنین با افزوده شدن هزار و ۱۱۵ نفر دیگر در ۲۴ ساعت گذشته، تاکنون ابتلای ۲۹۹ هزار و ۲۵۱ نفر به ویروس کرونا در این کشور اثبات شده است.
مرکز ملی آمار انگلیس دیروز اعلام کرد شمار واقعی جان باختگان از همه گیری کووید ۱۹، دستکم ۱۱ هزار نفر بیشتر از آمار دولت انگلیس است. تاکنون ۵۳ هزار و ۷۷ نفر در این کشور قربانی ویروس کرونا شده اند.
با عبور شمار مبتلایان به کرونا از ۲۰۰ هزار نفر، دولت شیلی قرنطینه را تشدید کرد
خبرگزاری رویترز گزارش داد: با عبور شمار مبتلایان به بیماری کرونا در شیلی از ۲۰۰ هزار نفر، دولت این کشور قرنطینه را تشدید و محدودیتهای تازهای را در سانتیاگو، پایتخت، اعلام کرد.
وزیر ورزش انگلیس: تماشاگران فوتبال باید مسابقات را از خانه تماشا کنندخبرگزاری رویترز گزارش داد:
اولیور دودن وزیر ورزش انگلیس روز چهارشنبه اعلام کرد تماشاگران فوتبال در این کشور باید مسابقات لیگ برتر را از خانه تماشا کنند. دودن گفت: «با تماشای مسابقات از خانه از دیگر تماشاگران و نیز جامعه خود مراقبت کنید.» وی افزود تماشاگران از ابتدای فصل آینده میتوانند به استادیومها باز گردند.
این اظهارات در حالی عنوان شد که فصل فوتبال انگلیس بعد از توقف بر سر کرونا در سه ماه پیش از سر گرفته شد.
سازمان جهانی بهداشت: دگزامتازون فقط برای افراد شدیدا بیمار استفاده شود
خبرگزاری رویترز گزارش داد: مایک رایان، مقام ارشد سازمان جهانی بهداشت گفت فوق العاده مهم است که داروی دگزامتازون فقط برای افراد شدیدا بیمار با وضعیت بحرانی استفاده شود.
پاناما تعلیق پروازهای بین المللی را یک ماه دیگر تمدید کرد
خبرگزاری رویترز گزارش داد: پاناما تعلیق پروازهای بین المللی را یک ماه دیگر تمدید کرد.
ممنوعیت برگزاری تجمعات بزرگ در آلمان دست کم تا پایان اکتبر
خبرگزاری رویترز گزارش داد: ایالتهای آلمان و دولت این کشور توافق کردند برگزاری تجمعات بزرگ را دست کم تا پایان اکتبر ممنوع کنند.
کارشناس: کرونا در حال گسترش در بستر جامعه آمریکاست
یک کارشناس امور بهداشتی در گفتگو با شبکه تلویزیونی سی ان ان، ضمن رد ادعای معاون رئیس جمهور آمریکا مبنی بر این که افزایش شدید شمار مبتلایان جدید به بیماری کووید-۱۹ در جنوب آمریکا صرفاً به علت افزایش تعداد تستهای کروناست که از مردم گرفته میشود، گفت: وقتی بر شمار مبتلایان جدید به کرونا در ایالتهای جنوبی و غربی آمریکا حتی تا ۱۵۰ درصد در روز اضافه میشود، این دیگر صرفاً ناشی از تست گرفتنهای بیشتر نیست، بلکه این روند به وضوح نشان میدهد که این همه گیری در حال گسترش (سریع) در بستر جامعه آمریکاست.
مجری سی ان ان گفت: اکنون با دکتر ازیکیئِل امانوئل، مشاور بهداشتی سابق کاخ سفید در دوران ریاست جمهوری باراک اوباما، گفتگو می کنم. من میخواهم از شما درباره اظهارات اخیر مایک پنس، معاون رئیس جمهور آمریکا، که عملکرد دولت ترامپ را در مقابله با بحران کرونا موفقیت آمیز توصیف کرده است، سؤالی بپرسم تا بتوانیم اظهارات وی را مورد بررسی قرار دهیم. آیا به نظر شما، این حقیقت که تاکنون، نزدیک به ۱۱۷ هزار آمریکایی بر اثر ابتلا به بیماری کووید-۱۹، جان باخته اند- همانطور که مایک پنس آن را توصیف میکند- یک داستان موفقیت آمیز است؟!
امانوئل گفت: به سختی میتوان چنین ادعایی را باور کرد. ما (آمریکا) در خصوص شمار جانباختگان و شمار سرانه کسانی که (نسبت به کل جمعیت کشور) بر اثر این بیماری کشته شده اند، تقریباً در صدر کشورهای جهان قرار داریم. ما در این زمینه حتی از کشور چین که این بیماری در آنجا آغاز شده است، نیز جلوتر هستیم، زیرا شمار مبتلایان و جانباختگانمان به مراتب از کشورهای ژاپن، تایوان و بسیاری دیگر از کشورهای جهان- مانند آلمان و امثال آن- که عملکرد به مراتب بهتری از ما (آمریکا) در زمینه کنترل این همه گیری داشته اند، بیشتر است.
وی افزود: اکنون چنین به نظر میرسد که دولت ترامپ میخواهد مسئله ویروس کرونا را پشت سر بگذارد و به مسائل دیگر (مانند بازگشایی ایالت ها) در این کشور بپردازد، اما ویروس کرونا هیچ تمایلی به همکاری (با دولت آمریکا) در این زمینه نشان نمیدهد (و همچنان در حال گسترش در سطح آمریکاست). متأسفانه، ما خودمان، با بازگشاییِ بسیار سریع و شتابزدهِ ایالتهای آمریکا، بر شمار مبتلایان جدیدی که بزودی شاهد آن خواهیم بود و همچنین بر شمار جانباختگان جدیدی که بزودی مشاهده خواهیم کرد، خواهیم افزود.
مجری گفت: به نظر میرسد که در اظهارات مایک پنس، معاون رئیس جمهور آمریکا، نوعی تناقض گویی نهفته باشد، زیرا وی اخیراً به فرمانداران ایالتهای آمریکا در کنفرانسی تلفنی گفته است که در رابطه با افزایش قابل ملاحظه شمار مبتلایان جدید به ویروس کرونا در ایالتهای جنوبی آمریکا، به مردم صرفاً بگویند که این به علت افزایش تعداد تست هاست، نه این که واقعاً بر شمار مبتلایان اضافه شده باشد. مثلاً در ایالتهای آریزونا، تگزاس، اوکلاهما و فلوریدا بر تعداد مبتلایان جدید به بیماری کووید-۱۹ به شدت افزوده شده است. آیا این صرفاً به علت افزایش تعداد تستهای کروناست، یا عوامل دیگری نیز در این فرایند دخیل هستند؟
امانوئل گفت: اجازه دهید من به دو نکته در این خصوص اشاره کنم. اول از همه، این که ما هنوز هم تقریباً همان تعداد از موارد ابتلای جدید به ویروس کرونا را در سراسر آمریکا داریم که در ماههای مارس، آوریل و مه (از اواسط اسفند ۱۳۹۸ تا اواسط اردیبهشت ۱۳۹۹) داشته ایم. ما در این برهه سه ماهه، همواره ۲۰ هزار مورد جدید ابتلا به کرونا در هر روز در آمریکا داشته ایم که صرفاً از ایالتهای نیویورک، نیوجرسی و کنتیکت (در شمال شرق آمریکا)، اکنون به ایالتهای جنوبی و غربی این کشور، منتقل شده اند.
از این رو، ما شاهد هیچ نوع کاهشی در مجموع مبتلایان جدیدِ روزانه به کرونا در سطح ملی (در آمریکا) نبوده ایم. البته در شمار جانباختگان روزانه به کرونا، کمی کاهش در سطح کشور دیده میشود که به این دلیل است که پزشکان، در مواجه با این بیماری، متبحرتر شده اند و بر تعداد دستگاههای تنفس مصنوعی که در اختیار بیمارستانها و کلینکها قرار گرفته است، نیز افزوده شده است.
البته این مطلب را نیز باید اضافه کنم که ممکن است به علت افزایش تعداد تستهای کرونا که از مردم گرفته میشود، درصد کمی بر مجموع مبتلایان جدید روزانه به کرونا در آمریکا اضافه شود، اما وقتی شما شاهد افزایش ۵۰ الی ۱۵۰ درصدی در شمار مبتلایان جدید روزانه به کرونا هستید، که ما هم اکنون در سراسر جنوب آمریکا شاهد آن هستیم، دیگر نمیتوانید مدعی شوید که این افزایشِ قابل توجه در تعداد مبتلایان جدید به کووید-۱۹، صرفاً به علت تست گرفتنهای بیشتر از مردم است! اینها موارد جدیدِ واقعی هستند که نشان میدهند این بیماری از طریق جامعه (بین مردم) در حال انتقال (سریع) است.
یکی دیگر از مسائلی که معاون رئیس جمهور (پنس) همواره تمایل دارد بگوید این است که اینها صرفاً شعلههایی هستند که ناگهان ظاهر شده اند (تشبیه مقابله با شیوع کرونا به تلاش آتش نشانان برای اطفاء حریق جنگل ها). این در حالی است که اینها اصلاً شعلههای کوچک و موقتی نیستند که ما بتوانیم به سرعت آنها را خاموش کنیم، بلکه افزایش شمار مبتلایان، روندی مستمر دارد.
ما شاهد ۲۰ هزار مورد ابتلای جدید در هر روز در آمریکا هستیم و حتی اگر این رقم به ۱۵ هزار مورد جدید در روز کاهش یابد، باز هم این به مثابه یک شعلهِ موقتی نیست که ما بتوانیم آن را به سرعت تحت کنترل درآوریم. این نشان میدهد که این بیماری در بستر جامعه در حال انتشار است. شما در شبکه سی ان ان نیز طی گزارشی، با یک خانم مصاحبه کردید که به یک رستوران رفته و در آنجا به کووید-۱۹ مبتلا شده بود که دقیقاً نشان میدهد این بیماری در جامعه آمریکا در حال شیوع (از هر فردِ مبتلا، به افراد دیگر) است.
هجوم پلیس به تظاهرات کادر درمان در فرانسه
کادر درمان فرانسه که از زمان آغاز بحران بهداشتی ناشی از ویروس کرونای جدید به طور گسترده بسیج شده بودند روز سه شنبه در چندین شهر این کشور تظاهرات کردند. در حاشیه تظاهرات کادر درمان در پاریس، درگیریهایی هم با نیروهای پلیس رخ داد.
شبکه خبری فرانسوی «ال ثای LCI» روز چهارشنبه در صفحه کاربری خود در توئیتر ویدیویی از رفتار جنجال برانگیز مأموران پلیس فرانسه با یکی از اعضای کادر درمانی منتشر کرد. در این ویدیو مأموران پلیس این زن پرستار ۵۱ ساله را در حالی که صورتش خونی شده بود بر روی زمین میکشیدند. این معترض که به نظر میرسید، آسم دارد به التماس از مأموران میخواست تا کیفش را به او بدهند تا اسپری تنفسی اش را استفاده کند. این صحنهها در شبکههای اجتماعی غوغا به پا کرد. بنژامن آمار، سخنگوی اتحادیه کارگری فرانسه در شهر "وال دو مارن" فرانسه گفت در ماههای مارس، آوریل و مه از تلاش پزشکان، پرستاران و دیگر اعضای کادر درمانی در فرانسه تقدیر شد و هم اکنون جایز نیست با این پرستار چنین رفتاری شود (مأموران میگویند این پرستار چندین سنگریزه به سمت پلیس پرتاب کرده و به آنها ناسزا گفته است).
اریک کوکرل، نماینده حزب «فرانسه تسلیم ناپذیر» نیز گفت: کاری که این پرستار انجام داده بود سزاوار چنین رفتاری نیست و وی را نباید بازداشت میکردند.
برگزاری امتحانات ورودی دانشگاهها در سوریه با وجود درگیریها و کووید ۱۹
جوانان سوری که از مناطق در اشغال گروههای تروریستی در شما سوریه برای ثبت نام به ویژه در دانشگاه حلب آمده اند با کنترلهای متعدد، چه در زمینه امنیتی و چه بهداشتی به علت همه گیری کووید ۱۹ مواجهند. اسپوتنیک با یک دانشجو و دو تن از مسئولان حوزه آموزش در سوریه گفتگو کرده است.
به گزارش خبرگزاری اسپوتنیک، گروههای مسلحی تروریستی که کنترل اکثر مناطق استان ادلب را برعهده دارند ترک این مناطق را برای جوانان حتی با هدف شرکت در آزمون ورودی دانشگاه ممنوع کرده اند. با این حال دمشق معتقد است تحصیلات عالی را در انحصار خود دارد و برای تضمین آن برای شهروندان خود، هرچه در توان دارد انجام میدهد. علی موسی، دانشجویی است که از منبج به حلب آمده است.
منبج در شرق حلب، در اشغال گروه های مسلح و نظامیان آمریکایی است. وزارت آموزش سوریه، شرایط لازم را فراهم آورده است تا جوانان سوری بتوانند در امتحان ورودی دانشگاه حلب شرکت کنند. علی موسی میگوید: دولت نه تنها به ما کمک کرد به حلب برسیم بلکه در زمان امتحانات به ما محل اقامت هم داده شد. این حمایت بسیار بزرگی است. مصطفی عبدالغنی، معاون واحد آموزش عالی حلب میگوید: ما آماده ایم متقاضیان را در مراکز ویژه مجهز با همه موارد احتیاطی اسکان دهیم. علاوه بر این، دانشجویان آینده، غذای رایگان نیز دریافت خواهند کرد.
یحیی عطار، مدیر گروه بهداشت آموزشی سوریه هم میگوید: پزشکان، همه دانشجویان آینده را بررسی کردند که هیچ نشانهای از آلودگی به ویروس کرونا نداشته باشند. آنها به بررسی ورودیهای جدید هم ادامه میدهند. وی گفت: ما در تمام مدت اقامت آنها در اینجا وضعیت سلامتشان را بررسی خواهیم کرد. مراکز اسکان هم هر روز ضد عفونی خواهند شد. اگر شرایط، طبق برنامه پیش روند حدود ۵۵۷ هزار رو ۳۴۸ جوان سوری، امتحانات ورود به دانشگاه را پشت سر خواهند گذاشت.